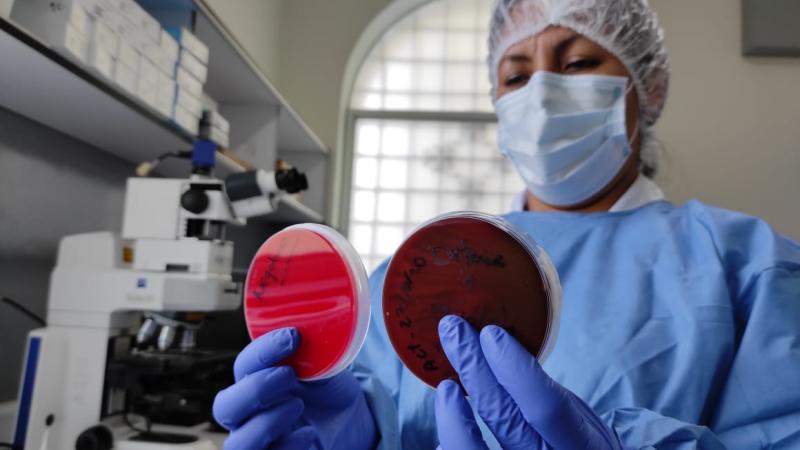

Difteria: una mujer de 69 años falleció a consecuencia de la enfermedad
Una paciente de 69 años falleció el pasado 30 de octubre a consecuencia de la difteria, informaron los especialistas de Epidemiología y Salud Ambiental de la Universidad Cayetano Heredia que han lanzado la alerta epidemiológica respectiva.
En un informe elevado al Ministerio de Salud (Minsa), los médicos indican que atendieron a la paciente el 29 de octubre. La mujer identificada con las siglas A.O.J. ingresó al hospital con un tiempo de enfermedad de 15 días, presentando tos, expectoración, disnea y debilidad generalizada, precisan.
[Lee también: ¿Qué es la difteria y cómo prevenirla?]
Dentro de los antecedentes patológicos, se resalta una historia de tuberculosis pulmonar en el 2010 con tratamiento completo por 6 meses, y secuela de bronquiectasias diagnosticadas en el citado nosocomio, indica el informe.
Actualmente, luego de notificarse el caso al Instituto Nacional de Salud (INS), se ha iniciado la investigación de los contactos de la paciente fallecida para la implementación del cerco epidemiológico con el aislamiento de quienes estuvieron más cerca, se inició la profilaxis antibiótica al personal de salud y la vacunación respectiva de aquellos que no hayan recibido la dosis de refuerzo.
Los especialistas recomiendan asimismo las tomas de hisopado nasal y faríngeo de los contactos cercanos y piden hacer el seguimiento de síntomas por 10 días desde el día de contacto con el caso confirmado.